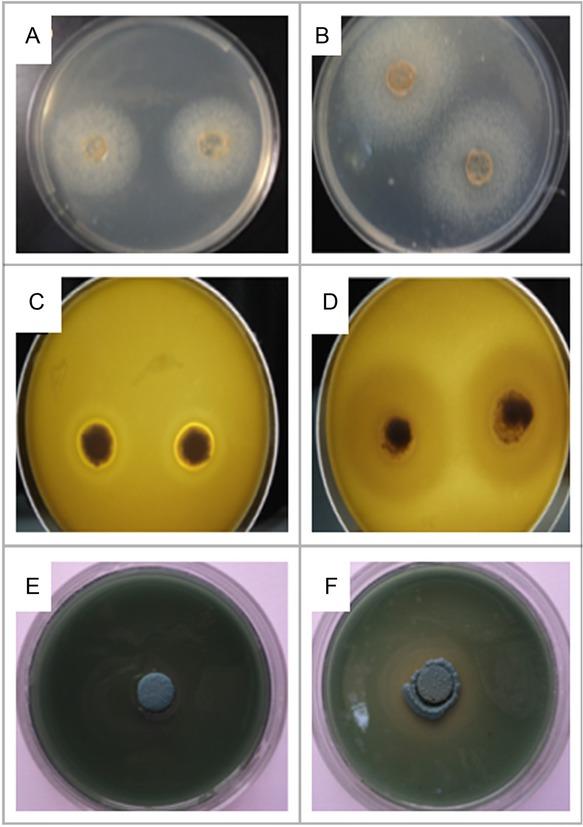

Malassezia species, members of the human healthy skin microbiota, may cause a wide range of cutaneous and systemic diseases in predisposed individuals. Thus, they exist at the interface between commensal and pathogen. Their interaction with the human immune system is of great interest, despite being members of the indigenous cutaneous microbial population (Pedrosa et al. 2014).
When the skin’s physical, chemical, or immunological mechanisms are altered, these yeasts can become pathogenic (Nardoni et al. 2005; Ashbee 2007; Bond 2010; Shokri et al. 2010; Gaitanis et al. 2012). Classic skin diseases caused by Malassezia yeasts include pityriasis versicolor (PV), seborrheic dermatitis, and Malassezia folliculitis.
Particular features of Malassezia organisms, such as its non-autoaggregation behavior and a very high lipolytic enzyme activity, may play an important role in the pathogenicity of parenteral lipid emulsion Malassezia related species (Kaneko et al. 2012).
Recently, the role of Malassezia lipases and phospholipases as pathogenicity mechanisms in seborrheic dermatitis was enhanced by demonstrating significantly increased lipase gene expression (Patiño-Uzcátegui et al. 2011). This finding was also supported by the in vitro induction of phospholipase activity of Malassezia seborrheic dermatitis isolates by β-endorphin, another putative virulence factor increased in inflammatory skin conditions (Vlachos et al. 2013).
Among keratinophilic microorganisms, Malassezia species can digest keratin, and it plays an important role in their growth and development.
A further health threat these pathogens impose is their propensity to develop biofilm on the skin and at the surface of indwelling medical devices. Biofilm represents a serious medical problem because it promotes resistance to antifungal drugs and acts as a reservoir for seeding infectious organisms at distant places (Cannizzo et al. 2007).
The present study aimed to quantify biofilm production and investigate the extracellular secretion of lipase, phospholipase, and keratinase for six Malassezia species by using microbiological and Real-Time reverse transcriptase qPCR methods. In addition, we examined whether virulence factors inherent in the organisms themselves might have clinical significance.
Isolates. Seventy-seven strains of Malassezia were included in the study: 20 Malassezia globosa, 10 Malassezia restricta, 14 Malassezia furfur, 7 Malassezia sympodialis, 5 Malassezia slooffiae, and 21 Malassezia pachydermatis. They were collected from patients with Malassezia folliculitis (12), from babies in a neonatal intensive care unit (20), pityriasis versicolor (10). As a comparison, a group of healthy subjects, 35 healthy individuals with no skin diseases and without any known underlying disease, were also included in this study. Samples were collected from healthy subjects’ backs, faces, and napes. These strains were identified by Real-Time qPCR using a specific hydrolysis probe as previously described (Ilahi et al. 2017).
Evaluation of biofilm formation by crystal violet staining (CVS). Biofilm formation by Malassezia species was assessed using crystal violet staining (CVS), as reported previously, with some modifications (Jin et al. 2003). The strains were cultured on Dixon agar at 32°C for three days. Thus, the culture was suspended in Dixon Liquid. The suspension (150 μl) was adjusted to match turbidity comparable to that of the 0.5 McFarland standard (106 CFU/ml), and 200 μl of Dixon Liquid were placed into selected wells of 96-well polystyrene microtiter plates (Kartell S.p.A., Italy). The plate was then incubated at 32°C on a shaker at 120 rpm. At 24 h, 200 μl of sterile Dixon Liquid was added and incubated for 48 h under the same conditions. Subsequently, the medium was removed, and each well was washed with sterile ultra-pure water.
For fixation of the biofilm, 200 μl of absolute methanol (15 min) were added and removed. The polystyrene microtiter plates were kept at room temperature for drying, and 200 μl of crystal violet (CV) (1% v/v) was added to each well and incubated for 5 min. Then, multiple washing with ultra-pure water was done until complete elimination of CV and finally, 200 μl of acetic acid was added.
A microtiter plate reader (Bio-Tek Synergy HT, Portugal) at 620 nm was used to read each well’s absorbance. The control absorbance values (containing no cells) were subtracted from the values for the test wells to eliminate spurious results due to background interference. Data were recorded as arithmetic means of absorbance values. Experiments were repeated as part of three independent assays, and we calculated the means of three repeats (Abs mean).
Evaluation of phospholipase production. The production of phospholipase was assessed using the egg-yolk plate method. Briefly, the isolates were incubated in Dixon agar. Thus, the culture was suspended in Dixon Liquid. Ten microliters of yeast suspension prepared from a fresh culture (106 cells/ml determined through densitometry) were spot inoculated in triplicate onto the medium and incubated at 32°C for 10 days. The formation of precipitation zones surrounding the colonies was considered an indication of enzyme production. The diameter of the colony (a) and the diameter of the precipitation zone plus the diameter of the colony (b) were measured. The phospholipase index was designated as Pz = a/b, as described by Coutinho and Paula (Coutinho and Paula 2000; Machado et al. 2010). According to this definition, low Pz values mean high enzymatic production; inversely, high Pz values indicate low enzymatic production. The enzymatic activity was scored into four categories: Pz of 1.0 indicated no enzymatic activity (null); Pz between 0.99 and 0.90 indicated weak enzymatic activity; Pz between 0.89 and 0.70 corresponded to high activity, and low Pz values ≤ 0.69 mean very high enzymatic activities.
Evaluation of lipase production. The strains were inoculated in triplicate on agar plates containing Tween® 80 as substrate (Bacto™ Peptone 10 g; sodium chloride 5 g; calcium chloride 0.1 g; agar 20 g; Tween® 80 20% 50 ml; water 950 ml) and incubated for seven days at 32°C. Precipitation halo and colony size were measured.
Degradation intensity was gauged by the ratio between colony diameter and precipitation halo (Pz). Pz coefficients were grouped into five classes: deficient group: Pz between 0.9 and 1, low group: Pz between 0.89–0.8, high group: Pz between 0.79–0.70; and very high group: Pz less than 0.69 or null (Pz = 1).
Evaluation of keratinase production. Keratin substrate (KS) was extracted from white chicken feathers. Ten grams of feathers were heated in 200 ml of DMSO (dimethylsulfoxide) for 2 hours at 100°C. The solution was precipitated for soluble keratin by using two volumes of cold acetone for one volume of the protein. Then, the caseous precipitate of keratin was suspended in 0.1 M of phosphate buffer. Afterward, soluble keratin was added to the solid medium at a concentration of 0.06%. The solid medium was inoculated with a micropipette by injecting 10 μl of standard suspension into the center of the Petri plate, and then incubated at 32°C. Control plates contained medium without keratin. The formation of precipitate zones around the colonies indicated keratinase production, and the zone was examined and measured. Pz coefficients were grouped into five classes as it was described for lipase activity.
Virulence gene expression. An RT-qPCR assay was newly developed to explore the virulence gene expression of 20 M. globosa isolates. The levels of mRNA and DNA copies keratinase (MGL_2332), lipase (LIP1 (MGL_0797)), phospholipase (MGL_3326), and the actin reference gene (ACT1) were measured.
The primers and probes were designed using Primer3 software (http://bioinfo.ut.ee/primer3-0.4.0), verified by using sequence manipulation suite software (http://bioinformatics.org/sms2) and were summarized in Table I.
The sequences of primers and probes used in RT-qPCR for gene expression studies in 20 Malassezia globosa isolates.
| Enzymes | Names | Sequences |
|---|---|---|
| Keratinase | KerF | 5’-ACGTCATGCTCAGATTGCAG-3’ |
| KerR | 5’-GACTTCCGCGAAGAACAAAG-3’ | |
| KerP | 5’-FAM-CACAATTGCTCCCGATACCT-MGB | |
| Lipase | LipF | 5’-ACCCAACATTTGCTTCGTTC-3’ |
| LipR | 5’-TCAATTATCAATGGTCGCGA-3’ | |
| LipP | 5’-FAM-CCTTGGTGGTCGTCAAAGTT-MGB | |
| Phospholipase | PhosF | 5’-AACTGGTGGATTTGCTGACC-3’ |
| PhosR | 5’-CTTTACGGGTCCAAGGTGAA-3’ | |
| PhosP | 5’-FAM-CCGTGTGCCATTCTACATTG-MGB | |
| Actin | ActF | 5’-CTCTCCTTGTACGCCTCTGG-3’ |
| ActR | 5’-TTGACAAGATGCTCCGTCAG-3’ | |
| ActP | 5’-TET-GTATTGTGCTGGACTCGGGT-MGB |
Cellular lysates were prepared from cells grown in culture in Dixon medium (reference) and lipase, keratinase, and phospholipase medium to mid-log phase using proteinase K (Qiagen®, Germany).
RNA was extracted from cellular lysates using the RNeasy Mini Kit (Qiagen®, Germany) according to the manufacturers’ instruction, and treated with DNase (Promega, USA).
For cDNA synthesis, 2.5 μl of total RNA was used as a template, and subsequent reverse transcription was performed using the PrimeScript RT Reagent Kit (Perfect Real Time) from TaKaRa (Shiga, Japan), following the manufacturer’s instructions.
The reaction mixture (20 μl) for the TaqMan assay contained 10 μl TaqMan Universal PCR Master Mix (Applied Biosystems, UK), 20 pmol of forward and reverse primers, 7 pmol of hydrolysis probe, and 1 μl of the template (extracted DNA or cDNA). The thermal conditions were as follows: initial holding stage at 50°C for 2 min and 95°C for 10 min, followed by 50 cycles at 95°C for 15 s and a final step at 54°C for 1 min. All reactions were performed in triplicate in 48-well reaction plates using a CFX 96 Real-Time System (Bio-Rad, USA) according to the MIQE guideline (available at: http://clinchem.aaccjnls.org/content/55/4/611).
Fold changes in the target gene expression were then normalized to the reference gene via the published comparative 2-ΔΔCq method according to the formula: RQ = 2 – (Cq target – Cq reference) tested – (Cq target – Cq reference) control (VanGuilder et al. 2008). Reference control was the isolate (TN371, KU597270) cultured in Dixon medium (keratinase (null), lipase (low), and phospholipase (low)). An expression change of 2.5 times or an increase in gene copy number was considered as a gene overexpression.
Statistical analysis. Statistical analyses were performed using IBM SPSS software (version 20.0; IBM SPSS Inc., USA). Categorical variables were compared using the χ2 or Fisher’s exact test and continuous variables by the ANOVA test. A p-value of 0.05 was considered significant. Pearson’s correlation coefficient (r) was calculated to measure the correlation between different virulence factors. Where the value was equal to 1, it meant a perfect positive correlation, the value r = 0 meant no correlation, and the value of –1 meant a perfect negative correlation.
Biofilm formation. All Malassezia species formed biofilm (Fig. 1). The biofilm formation was estimated in triplicate, and an average was calculated for each isolate (Fig. 1). The absorbance for crystal violet after biofilm staining was as follows: 0.322 ± 0.01 for M. globosa, 0.336 ± 0.01 for M. furfur, 0.336 ± 0.02 for M. restricta, 0.349 ± 0.02 for M. pachydermatis, 0.256 ± 0.02 for M. slooffiae, and 0.235 ± 0.02 for M. sympodialis (Table II).

Different Malassezia species biofilm quantification after crystal violet staining (Abs CV). Error bars represent a standard deviation.
No statistically significant difference was observed between Malassezia species in biofilm formation (p = 0.567). Strains collected from neonates had the highest biofilm production (Abs mean = 0.396 ± 0.02), followed by strains from folliculitis (Abs mean = 0.342 ± ± 0.01), and pityriasis versicolor (Abs mean = 0.313 ± 0.02). However, there was no statistically significant association between the biofilm-forming ability and the clinical origin of the isolates (p = 0.570). Strains isolated from the control group formed biofilms to a lesser degree (Abs mean = 0.291 ± 0.02) (Table II). Furthermore, we noted that the total biofilm biomass formed in vitro by Malassezia isolates from patients was higher than those formed by Malassezia healthy skin isolates (p = 0.02).
Biofilm production by Malassezia species isolated from different clinical sites.
| Groups | Malassezia globosa | Malassezia restricta | Malassezia furfur | Malassezia sympodialis | Malassezia slooffiae | Malassezia pachydermatis | Total | ||||||
|---|---|---|---|---|---|---|---|---|---|---|---|---|---|
| Mean Abs ±SD | Range | Mean Abs ±SD | Range | Mean Abs ±SD | Range | Mean Abs ±SD | Range | Mean Abs ±SD | Range | Mean Abs ±SD | Range | Mean Abs ±SD | |
| Folliculitis (N= 12) | 0.321 ±0.01 | 0.155-0.41 | 0.366 ±0.01 | 0.301-0.398 | 0.339 ±0.01 | 0.317-0.594 | 0 | 0 | 0 | 0.342±0.01 | |||
| Neonates (N = 20) group | 0 | 0 | 0.433 ±0.02 | 0 | 0 | 0.361 ±0.02 | 0.30-0.54 | 0.396 ±0.02 | |||||
| Pityriasis versicolor (N = 10) | 0.317±0.01 | 0.16-0.604 | 0.306 ±0.02 | 0.316 ±0.02 | 0 | 0 | 0 | 0.313 ±0.02 | |||||
| Control (N = 35) group | 0.328±0.01 | 0.18-0.51 | 0.338±0.02 | 0.12-0.311 | 0.255 ±0.02 | 0.12-0.311 | 0.235±0.02 | 0.137-0.361 | 0.256±0.02 | 0.167-0.331 | 0.336 ±0.02 | 0.22-0.44 | 0.291 ±0.02 |
| Total | 0.322 ±0.01 | 0.155-0.604 | 0.336 ±0.02 | 0.12-0.572 | 0.336 ±0.02 | 0.12-0.594 | 0.235±0.02 | 0.137-0.362 | 0.256 ±0.03 | 0.167-0.332 | 0.349 ±0.02 | 0.22-0.54 | |
N - number of tested isolates; SD - standard deviation
Lipase activity. All Malassezia species displayed lipase activity (Fig. 2). Nineteen isolates of M. globosa (95%) (Pz = 0.55 ± 0.02) and five isolates of M. sympodialis (71.43%) (Pz = 0.54 ± 0.02) showed a very high enzymatic activity (Table III).
Malassezia species colonies of A) high lipase activity, B) very high lipase activity, C) high phospholipase activity, D) very high phospholipase activity, E) keratinase activity null, F) very high keratinase activity.
Strains isolated from pityriasis versicolor showed very high activity with Pz values between 0,28 and 0.36 (Table IV). Nevertheless, no statistically significant difference was observed between the mean lipase indices for different Malassezia species inducing different pathologies (p = 0.356).
Level of phospholipase, lipase, and keratinase production by Malassezia species.
| Phospholipase activity number of isolates (rate of isolates) | Lipase activity number of isolates (rate of isolates) | Keratinase activity number of isolates (rate of isolates) | |||||||||
|---|---|---|---|---|---|---|---|---|---|---|---|
| Mean (Pz) ±SD | very high n (%) | high n (%) | Nul n (%) | Mean (Pz) ± SD | very high n (%) | high n (%) | Mean (Pz) ± SD | very high n (%) | high n (%) | null | |
| Malassezia globosa (N = 20 ) | 0.64 ±0.03 | 9(45) | 11 (55) | 0(0) | 0.55±0.02 | 19 (95) | 1(5) | 0.65±0.02 | 10 (50) | 6 (30) | 4(20) |
| Malassezia restricta (N = 10) | 0.76 ±0.02 | 0(0) | 7(70) | 3 (30) | 0.36 ±0.03 | 10 (100) | 0(0) | 0.69 ±0.02 | 0(0) | 2 (20) | 8 (80) |
| Malassezia furfur (N = 14) | 0.64 ±0.02 | 2 (14.29) | 12 (85.71) | 0(0) | 0.45 ±0.03 | 14 (100) | 0(0) | 0.67±0.02 | 1(7.15) | 6 (42.85) | 7(50) |
| Malassezia sympodialis (N = 7) | 0.67 ±0.02 | 1 (14.29) | 6 (85.71) | 0(0) | 0.54 ±0.02 | 5 (71.43) | 2 (28.57) | 0.62 ±0.03 | 1 (14.3) | 3 (42.85) | 3 (42.85) |
| Malassezia slooffiae (N = 5) | 0.64 ±0.02 | 2(40) | 3 (60) | 0(0) | 0.4 ±0.04 | 5(100) | 0(0) | 0.67±0.02 | 2(40) | 3 (60) | 0(0) |
| Malassezia pachydermatis (N = 21) | 0.64 ±0.03 | 9 (42.86) | 12 (57.14) | 0(0) | 0.31 ±0.02 | 21 (100) | 0(0) | 0.68±0.02 | 3 (14.29) | 8 (38.5) | 10 (47.66) |
| Total | 0.66 ±0.02 | 23 (29.87) | 51 (66.23) | 3(3.9) | 0.48 ±0.02 | 74 (91.1) | 3 (3.9) | 0.66 ±0.02 | 17(22.08) | 28 (36.36) | 32 (41.56) |
N - number of tested isolates
n - number of isolates with positive activity for the corresponding hydrolytic enzyme
SD - standard deviation
However, a statistically significant difference was noted in lipase activity between M. globosa isolates from pityriasis versicolor and healthy skin (p = 0.001).
Phospholipase activity. All isolates of M. furfur, M. globosa, M. sympodialis, M. slooffiae and M. pachydermatis included in this study demonstrated a high or very high phospholipase activity (Fig. 2). However, only 70% of the M. restricta isolates showed high activity (Table III). A high activity level with Pz values (0.66 ± 0.02) was found in 95% of isolates from neonates (Table IV).
Enzymatic activities of Malassezia species isolated from different clinical sites.
| Folliculitis (N = 12) | Neonates group (N = 20) | Pityriasis versicolor (N = 10) | Control group (N = 35) | ||
|---|---|---|---|---|---|
| Phospholipase activity Mean (Pz) ± SD | Malassezia globosa (N = 20) | 0.69 ± 0.01 (5/12) | – (0/20) | 0.74 ± 0.02 (8/10) | 0.73 ± 0.02 (7/35) |
| Malassezia restrict (N = 10) | 0.67 ± 0.01 (1/12) | – (0/20) | 0.8 ± 0.02 (1/10) | 0.83 ± 0.02 (8/35) | |
| Malassezia furfur (N = 14) Malassezia sympodialis (N = 7) | 0.74 ± 0.01 (6/12) – (0/12) | 0.70 ± 0.02 (1/20) – (0/20) | 0.69 ± 0.02 (1/10) – (0/10) | 0.71 ± 0.01 (6/35) 0.78 ± 0.02 (7/35) | |
| Malassezia slooffiae (N = 5) | 0 (0/12) | – (0/20) | – (0/10) | 0.77 ± 0.02 (5/35) | |
| Malassezia pachydermatis(N = 21) | 0 (0/12) | 0.66 ± 0.02 (19/20) | – (0/10) | 0.79 ± 0.01 (2/35) | |
| Total | 0.70 ± 0.01 | 0.68 ± 0.02 | 0.74 ± 0.02 | 0.77 ± 0.02 | |
| Lipase activity Mean (Pz) ± SD | Malassezia globosa (N = 20) | 0.36 ± 0.01 (5/12) | – (0/20) | 0.36 ± 0.02 (8/10) | 0.38 ± 0.02 (7/35) |
| Malassezia restricta (N = 10) | 0.37 ± 0.01 (1/12) | – (0/20) | 0.32 ± 0.02 (1/10) | 0.36 ± 0.02 (8/35) | |
| Malassezia furfur (N = 14) Malassezia sympodialis (N = 7) | 0.32 ± 0.02 (6/12) – (0/12) | 0.39 ± 0.02 (1/20) – (0/20) | 0.28 ± 0.01 (1/10) – (0/10) | 0.36 ± 0.02 (6/35) 0.48 ± 0.02 (7/35) | |
| Malassezia slooffiae (N = 5) | – (0/12) | – (0/20) | – (0/10) | 0.4 ± 0.01 (5/35) | |
| Malassezia pachydermatis (N = 21) | – (0/12) | 0.31 ± 0.01 (19/20) | – (0/10) | 0.38 ± 0.02 (2/35) | |
| Total | 0.35 ± 0.02 | 0.35 ± 0.02 | 0.32 ± 0.02 | 0.39 ± 0.02 | |
| Keratinase activity Mean (Pz) ± SD | Malassezia globosa (N = 20) | 0.75 ± 0.02 (5/12) | – (0/20) | 0.62 ± 0.02 (8/10) | 0.85 ± 0.02 (7/35) |
| Malassezia restricta (N = 10) | 1 (1/12) | – (0/20) | 0.65 ± 0.02 (1/10) | 1 (8/35) | |
| Malassezia furfur (N = 14) Malassezia sympodialis (N = 7) | 0.82 ± 0.02 (6/12) – (0/12) | 0.53 ± 0.02 (1/20) – (0/20) | 0.65 ± 0.02 (1/10) – (0/10) | 0.96 ± 0.02 (6/35) 0.84 ± 0.02 (7/35) | |
| Malassezia slooffiae (N = 5) | – (0/12) | – (0/20) | – (0/10) | 0.8 ± 0.02 (5/35) | |
| Malassezia pachydermatis (N = 21) | – (0/12) | 0.85 ± 0.02 (19/20) | – (0/10) | 0.79 ± 0.02 (2/35) | |
| Total | 0.86 ± 0.02 | 0.69 ± 0.02 | 0.64 ± 0.02 | 0.873 ± 0.02 | |
N– number of tested isolates; SD – standard deviation
No statistically significant difference was observed between the mean phospholipase production of Malassezia species inducing different pathologies (p = 0.65). However, a statistically significant difference between pityriasis versicolor isolates and healthy skin isolates was noted for M. globosa phospholipase activity (p = 0.001).
Keratinase activity. The Pz values for the keratinase activity of Malassezia isolates ranged from 0.33 to 0.91. All M. slooffiae strains showed positive keratinase activity (Fig. 2), and 40% were shown to be very high producers (Table III).
Sixteen isolates of M. globosa (80%) (Pz = 0.65 ± 0.02), four isolates of M. sympodialis (57.15%) (Pz = 0.62 ± 0.03), seven isolates of M. furfur (50%) (Pz = 0.67 ± 0.02), two isolates of M. restricta (20%) (Pz = 0.69 ± 0.02), and 11 isolates M. pachydermatis (52.29%) (Pz = 0.68 ± 0.02) showed keratinase activity (Table III).
A statistically significant difference was observed between the mean keratinase indices of M. slooffiae and the other Malassezia species (p = 0.005). In addition, a statistically significant difference between M. globosa isolates from pityriasis versicolor and healthy skin was noted for keratinase activity (p = 0.001).
A positive correlation between secretion of keratinase and phospholipase (r = 0.31, p < 0.001) was also observed.
Expression of keratinase, lipases, and phospholipases of M. globosa. RT-qPCR was used for the quantitative study on the expression and copy number of three genes (encoding keratinase, lipase, and phospholipase) responsible for the virulence of 20 M. globosa strains collected from patients with folliculitis (5), pityriasis versicolor (8), and a control group (7). Their expression was compared to the ACT1 gene and the isolates (TN371, KU597270) cultured in the Dixon medium. The overexpression of one or more genes was observed in 5/5 (100%) of strains isolated from patients with folliculitis, in 7/8 (87.5%) from pityriasis versicolor isolates, and in 3/7 (42.85%) control group isolates (Table V). The increase in expression of keratinase varied from 0.81 to 3.52 folds and the increase of lipase varied from 1.84 to 12.99 folds in folliculitis strains. The phospholipase’s highest expression level was 12.4 folds in the S3 isolate collected from folliculitis (Table V). Upregulation of the enzyme expression was noted in strains collected from the control group as follows: lipase in only one isolate; and keratinase and phospholipase in two isolates. A statistically significant difference in the lipase gene expression (p = 0.042) was observed in the strains collected from patients with folliculitis compared to the group control. The overproduction of three genes was observed in five strains (S2, S3, S7, S10, and S13). The overexpression of the keratinase, lipase, and phospholipase genes was associated with an increased copy number of the corresponding genes in eight strains of M. globosa (Table V).
Relative quantification of gene expression and keratinase, lipase, and phospholipase genes copy number in 20 Malassezia globosa strains.
| ID | Clinical sites | RNA relative quantification | DNA relative quantification | ||||
|---|---|---|---|---|---|---|---|
| Keratinase | Lipase | Phospholipase | Keratinase | Lipase | Phospholipase | ||
| S1 | Folliculitis | 2.11 | 1.84 | 2.59 | 4.43 | 7.22 | 3.06 |
| S2 | Folliculitis | 2.52 | 7.51 | 7.57 | 1.36 | 2.04 | 1.08 |
| S3 | Folliculitis | 3.52 | 12.99 | 12.40 | 1.50 | 2.12 | 3.36 |
| S4 | Folliculitis | 0.81 | 3.20 | 3.91 | 0.32 | 12.98 | 0.69 |
| S5 | Folliculitis | 3.40 | 5.55 | 1.48 | 6.58 | 9.57 | 6.36 |
| S6 | Pityriasis versicolor | 0.49 | 0.31 | 0.78 | 0.29 | 0.21 | 0.02 |
| S7 | Pityriasis versicolor | 2.65 | 3.52 | 3.17 | 1.35 | 1.46 | 1.10 |
| S8 | Pityriasis versicolor | 2.82 | 2.35 | 2.54 | 2.79 | 7.43 | 1.34 |
| S9 | Pityriasis versicolor | 1.25 | 3.10 | 2.53 | 0.77 | 1.60 | 0.24 |
| S10 | Pityriasis versicolor | 2.57 | 2.55 | 2.52 | 1.96 | 1.56 | 3.33 |
| S11 | Pityriasis versicolor | 2.84 | 2.75 | 1.32 | 0.97 | 1.74 | 1.03 |
| S12 | Pityriasis versicolor | 0.96 | 2.86 | 3.37 | 0.46 | 0.86 | 2.56 |
| S13 | Pityriasis versicolor | 2.55 | 2.86 | 3.38 | 1.50 | 2.58 | 1.88 |
| S14 | Control group | 1.53 | 0.53 | 0.56 | 1.42 | 0.82 | 0.75 |
| S15 | Control group | 1.04 | 1.19 | 2.55 | 0.92 | 1.05 | 0.86 |
| S16 | Control group | 0.67 | 1.36 | 0.48 | 0.50 | 0.61 | 0.32 |
| S17 | Control group | 0.94 | 2.37 | 2.43 | 0.50 | 1.06 | 2.33 |
| S18 | Control group | 2.36 | 0.07 | 0.48 | 1.87 | 0.26 | 0.49 |
| S19 | Control group | 0.24 | 2.52 | 2.80 | 0.56 | 1.31 | 1.39 |
| S20 | Control group | 2.51 | 3.30 | 1.50 | 1.31 | 1.18 | 0.27 |
In addition, correlation analysis with Pearson’s coefficient revealed a statistically significant positive association between the production of the enzymes and the expression of their genes: keratinase (r = 0.881, p < 0.0001), lipase (r = 0.530, p = 0.016), and phospholipase (r = 0.754, p = 0.0001).
In the present study, we examined multiple virulence factors, such as extracellular secreted hydrolytic enzymes and biofilm development which contribute to the ability of Malassezia species to colonize host tissues and cause disease. However, only a few studies focused on virulence factors’ expression and pathogenesis of the Malassezia species. Our results demonstrated that all Malassezia species included in our study, like many other fungal and bacterial species, produced biofilms (Davey and O’Toole 2000).
A better knowledge of the mechanisms of antifungal drug resistance may lead to developing novel therapies for biofilm-based diseases. Multiple mechanisms have been proposed for the biofilm resistance (Mukherjee and Chandra 2004). Metabolic quiescence has been proposed as a mechanism of antimicrobial resistance in biofilm bacteria (Mah and O’Toole 2001) and fungi (Mukherjee and Chandra 2004). However, our data revealed that CVS staining showed biofilm cells to be active in our Malassezia species, in line with previous data for Candida albicans and Candida parapsilosis (Kuhn et al. 2002). Therefore, biofilm production is unlikely to significantly promote the antifungal resistance of Malassezia species (Mukherjee and Chandra 2004). Biofilm production has been studied only for M. furfur (Simonetti et al. 2016; Angiolella et al. 2018) and M. pachydermatis (Figueredo et al. 2012). Angiolella et al. (2018) demonstrated that biofilm adherence and hydrophobicity are virulence factors in M. furfur. Also, these studies showed that M. pachydermatis strains from dogs with or without skin lesions can form a biofilm with variable quantity and structures, which are likely to be strain-dependent (Figueredo et al. 2012).
In our study, we showed that all Malassezia species produced lipase, and 95% of M. globosa showed a very high enzymatic activity. Lipases catalyze the hydrolysis of ester bonds of triacylglycerols, resulting in the release of fatty acids. In almost all organisms, lipases play essential roles in lipid metabolism, including digestion, transport, and processing of dietary lipids. Lipases also play essential roles in the virulence of skin-associated lipophilic fungal pathogens such as Malassezia spp. The gene that encodes lipase in M. furfur, M. pachydermatis, and M. globosa has been identified, and the recent genome sequencing efforts have revealed at least 14 lipase-encoding genes in M. globosa (Figueredo et al. 2012). Juntachai et al. (2009) suggested that lipase may be a pathogenic factor in Malassezia skin disease and explained why M. globosa is an important pathogenic species in several human skin diseases despite its slow rate of growth (Jin et al. 2003). We showed a high lipase activity from M. globosa strains isolated from pityriasis versicolor. In the previous studies, M. globosa, one of the most frequently isolated Malassezia spp. from patients with dandruff and seborrheic dermatitis, displayed extracellular lipase activity (Plotkin et al. 1996; DeAngelis et al. 2007; Vlachos et al. 2013).
Phospholipase activity exhibited by pathogenic microorganisms is another virulence factor that permits hydrolyzing one or more ester linkages in glycerophospholipids, releasing free fatty acids. In this study, all strains could express phospholipase except for M. restricta. Only 70% of isolates of this species were phospholipase producers. Additionally, we noted a high phospholipase activity for Malassezia isolates recovered from neonates. This virulence factor intrinsic to Malassezia yeasts has been discussed in association with the pathogenesis of seborrheic dermatitis. The increased level of production of phospholipase has been shown only for pathogenic M. pachydermatis strains (Cannizzo et al. 2007).
Current information on phospholipases in Malassezia spp. is limited. Juntachai et al. (2009) detected extracellular phospholipase activities in M. furfur, M. pachydermatis, M. slooffiae, M. sympodialis, M. globosa, M. restricta, and M. obtusa. However, enzyme activity was higher only in M. pachydermatis (Juntachai et al. 2009). The ability to express enzymes not only varied among different species of Malassezia but also differed among the strains of the same species isolated from different clinical manifestations. We showed a statistically significant difference in M. globosa phospholipase activity between pityriasis versicolor isolates and healthy skin isolates. The production of Malassezia phospholipases on the skin could result in the removal of epidermal lipids, disruption of the epidermal barrier function, and the development of seborrheic dermatitis when sebum production is constitutionally decreased (Cannizzo et al. 2007).
Keratinases are proteolytic enzymes in nature. They mainly attack the disulfide bond of the keratin substrate (Böckle et al. 1995; Gupta and Ramnani 2006). As previously reported, the dermatophytes and non-dermatophytes species were both keratinase producers capable of damaging the keratinized structure of the skin (Yu et al. 1971; Takiuchi et al. 1984; Gupta and Ramnani 2006). In our study, all M. slooffiae isolates were keratinase producers. However, only half of M. furfur had positive enzymatic activity. Peyton et al. found that M. furfur can degrade keratin (Gupta and Ramnani 2006; Peyton et al. 2012). However, Gupta and Ramnani (2006) reported a lack of keratinase activity of M. furfur.
Our study found a positive correlation between the secretion of keratinase and phospholipase. These virulence factors appear to act synergistically to contribute to the virulence of Malassezia strains. The high enzymatic activity shown in our Malassezia isolates could be responsible for this yeast changing from a commensal to a pathogenic status.
Malassezia isolates from patients with different pathologies had an enzymatic activity (p = 0.001) and biofilm biomass (p = 0.02) significantly higher than those isolated from healthy individuals. This observation suggests that the enzymatic activity of Malassezia may play a role in the onset of skin lesions. Others confirm these results (Pini and Faggi 2011; Angiolella et al. 2018).
The genome sequencing data revealed that M. globosa possesses the genes encoding for 14 lipases and nine phospholipases. Among them, four lipases (MGL_3878, MGL_3507 MGL_0799, and MGL_0798) and two phospholipases (MGL_4252 and MGL_3326) were expressed on human scalps (Xu et al. 2007). Based on the activity and expression levels of MgLip2 in M. globosa, the Lip lipase family appears to have the highest impact on the pathogenicity of M. globosa (Sommer et al. 2016; Lan et al. 2017). Few studies were carried out to analyze the expression of lipases and phospholipases of the fungus (Brunke and Hube 2006). However, to our knowledge, no information is currently available for the expression of keratinase. In our study, the RT-qPCR analysis of the expression and copy number of these genes in 20 M. globosa isolates showed the overexpression of one or more genes in 5/5 isolates from folliculitis and 7/8 from pityriasis versicolor. The phospholipase’s highest expression level was 12.4 folds by the isolates collected from folliculitis.
Moreover, we noted a statistically significant difference in the lipase gene expression (p = 0.042) that was higher in the strains collected from patients with folliculitis compared to the control group. These data imply a possible role of lipase in the host environment to produce free fatty acids for the fungus. The concurrent overproduction of three genes was observed in five strains isolated from patients with folliculitis and pityriasis versicolor. However, overexpression was noted in only two control group cases, suggesting that these enzymes play an important role in the pathogenicity of Malassezia disorder inducing a transition from colonization to infection. Interestingly, further studies evaluated the expression of lipases and phospholipases of M. restricta in patients with seborrheic dermatitis and suggested that the most of the patients’ isolates expressed these enzymes (Lee et al. 2013).
Moreover, Patiño-Uzcátegui et al. (2011) found a significantly higher expression of Mgl0797, Mgl0798, and Mflip1 virulence genes in seborrheic dermatitis HIV patients. They concluded that lipases may be related to developing seborrheic dermatitis and could be considered virulence factors.
In the study of Aghaei Gharehbolagh et al. (2018), RT-PCR was used to investigate the contribution of the MGL_3741 gene to the pathogenicity of M. globosa in pityriasis versicolor. These authors revealed that this gene can be related to the yeast’s pathogenicity and is a candidate for the new antifungal search for a better treatment of pityriasis versicolor (Aghaei Gharehbolagh et al. 2018). However, further studies are still needed to determine its role.
This investigation provides more information about the production frequency of the significant enzymes considered virulence factors of Malassezia species. Interestingly, the overexpression of one or more genes was observed in strains isolated from patients with the Malassezia disorder. These data emphasize the role of lipase and phospholipase in the pathogenicity of this fungus and suggest that these enzymes can act synergistically in Malassezia-induced pathologies.